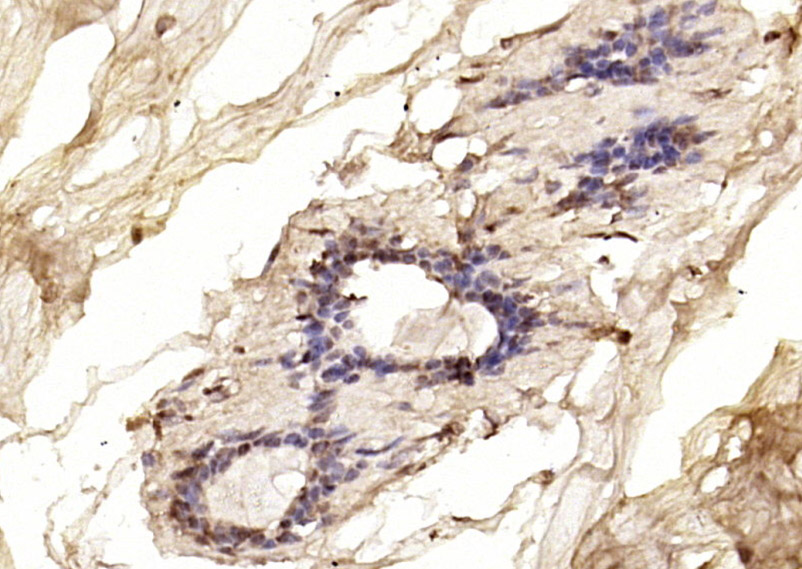
产品细节图片3

相关产品推荐更多 >

RHOG Rabbit pAb, BF750 conjugated(bs-10466R-BF750)-100ul
¥2980
AchE isoform H Rabbit pAb(bs-21684R)-50ul/100ul/200ul
¥1180
SARS-CoV-2 (2019-nCoV) Nucleocapsid Rabbit pAb(bs-24386R)-50ul/100ul/200ul
¥1180
KCNQ2 Rabbit pAb, PE-Cy5 conjugated(bs-11728R-PE-Cy5)-100ul
¥2980
IL-4R Rabbit pAb(bs-41425R)-50ul/100ul/200ul
¥1180
万千商家帮你免费找货
0 人在求购买到急需产品
- 详细信息
- 文献和实验
- 技术资料
- 应用范围:
产品信息以Bioss网站为准
- 规格:
50ul/100ul/200ul
| 规格: | 50ul | 产品价格: | ¥1180.0 |
|---|---|---|---|
| 规格: | 100ul | 产品价格: | ¥1980.0 |
| 规格: | 200ul | 产品价格: | ¥2800.0 |
| 产品编号 | bs-0802R |
| 英文名称 | BRCA1 Rabbit pAb |
| 中文名称 | 乳腺癌易感基因1抗体 |
| 英文别名 | BRCA 1; BRCA1/BRCA2 containing complex subunit 1; BRCA1/BRCA2-containing complex, subunit 1; BRCA1_HUMAN; BRCAI; BRAC 1; BRCA 1; BRCC 1; BRCC1; Breast Cancer 1; Breast Cancer 1 Early Onset; Breast cancer type 1 susceptibility protein; Breast and ovarian cancer susceptibility protein 1; Breast Ovarian Cancer Susceptibility; IRIS; Papillary Serous Carcinoma Of The Peritoneum; PSCP; RING finger protein 53; BROVCA1; IRIS; PNCA4; PPP1R53; Protein phosphatase 1 regulatory subunit 53; RNF53; BAP1. |
| 产品应用 | IHC-P=1:100-500, IHC-F=1:100-500, IF=1:100-500 Not yet tested in other applications. |
| 交叉反应 | Human |
| 抗体来源 | Rabbit |
| 免疫原 | KLH conjugated synthetic peptide derived from human BRCA1 |
| 亚型 | IgG |
| 性状 | Liquid |
| 纯化方法 | affinity purified by Protein A |
| 克隆类型 | Polyclonal |
| 理论分子量 | 208 kDa |
| 浓度 | 1mg/ml |
| 储存液 | 0.01M TBS (pH7.4) with 1% BSA, 0.02% Proclin300 and 50% Glycerol. |
| 研究领域 | Cancer > Oncoproteins/suppressors > Tumor suppressors Cell Biology > Proteolysis / Ubiquitin > Proteasome / Ubiquitin > Ubiquitin E3 Enzymes > RING Finger E3 Ligase Epigenetics and Nuclear Signaling > Chromatin Modifying Enzymes > Ubiquitylation Epigenetics and Nuclear Signaling > DNA / RNA > DNA Damage & Repair > DNA Damage Response > BRCA1 Epigenetics and Nuclear Signaling > Transcription > Cancer susceptibility > Tumor Suppressors |
| 亚基 | Heterodimer with BARD1. Part of the BRCA1-associated genome surveillance complex (BASC), which contains BRCA1, MSH2, MSH6, MLH1, ATM, BLM, PMS2 and the RAD50-MRE11-NBN protein complex. This association could be a dynamic process changing throughout the cell cycle and within subnuclear domains. Component of the BRCA1-A complex, at least composed of the BRCA1, BARD1, UIMC1/RAP80, FAM175A/Abraxas, BRCC3/BRCC36, BRE/BRCC45 and BABAM1/NBA1. Interacts (via BRCT domains) with FAM175A/Abraxas and RBBP8. Associates with RNA polymerase II holoenzyme. Interacts with SMC1A and COBRA1/NELFB. Interacts (via BRCT domains) with phosphorylated BRIP1. Interacts with FANCD2 (ubiquitinated). Interacts with BAP1. Interacts with DCLRE1C/Artemis and CLSPN. Interacts with H2AFX (phosphorylated on 'Ser-140'). Interacts with CHEK1 and CHEK2. Interacts with BRCC3. Interacts (via BRCT domains) with ACACA (phosphorylated); the interaction prevents dephosphorylation of ACACA. Interacts with AURKA. Interacts with UBXN1. Part of a trimeric complex containing BRCA1, BRCA2 and PALB2. Interacts with PALB2 and this interaction is essential for its function in HRR. Interacts with BRCA2 only in the presence of PALB2 which serves as the bridging protein. |
| 亚细胞定位 | Cytoplasm; Nucleus. Localizes at sites of DNA damage at double-strand breaks (DSBs) and recruitment to DNA damage sites is mediated by the BRCA1-A complex. |
| 组织特异性 | Isoform 1 and isoform 3 are widely expressed. Isoform 3 is reduced or absent in several breast and ovarian cancer cell lines. |
| 翻译后修饰 | Phosphorylation at Ser-308 by AURKA is required for normalcell cycle progression from G2 to mitosis. Phosphorylated inresponse to IR, UV, and various stimuli that cause checkpointactivation, probably by ATM or ATR. Phosphorylation at Ser-988 byCHEK2 regulates mitotic spindle assembly. Autoubiquitinated, undergoes 'Lys-6'-linkedpolyubiquitination. 'Lys-6'-linked polyubiquitination does notpromote degradation. |
| 相似性 | Contains 2 BRCT domains.
Contains 1 RING-type zinc finger. |
| 功能 | E3 ubiquitin-protein ligase that specifically mediatesthe formation of 'Lys-6'-linked polyubiquitin chains and plays acentral role in DNA repair by facilitating cellular responses toDNA damage. It is unclear whether it also mediates the formation ofother types of polyubiquitin chains. The E3 ubiquitin-proteinligase activity is required for its tumor suppressor function. TheBRCA1-BARD1 heterodimer coordinates a diverse range of cellularpathways such as DNA damage repair, ubiquitination andtranscriptional regulation to maintain genomic stability. Regulatescentrosomal microtubule nucleation. Required for normal cell cycleprogression from G2 to mitosis. Required for appropriate cell cyclearrests after ionizing irradiation in both the S-phase and the G2phase of the cell cycle. Involved in transcriptional regulation ofP21 in response to DNA damage. Required for FANCD2 targeting tosites of DNA damage. May function as a transcriptional regulator.Inhibits lipid synthesis by binding to inactive phosphorylatedACACA and preventing its dephosphorylation. Contributes tohomologous recombination repair (HRR) via its direct interactionwith PALB2, fine-tunes recombinational repair partly through itsmodulatory role in the PALB2-dependent loading of BRCA2-RAD51repair machinery at DNA breaks. Component of the BRCA1-RBBP8complex which regulates CHEK1 activation and controls cell cycleG2/M checkpoints on DNA damage via BRCA1-mediated ubiquitination ofRBBP8. |
| 保存条件 | Shipped at 4℃. Store at -20℃ for one year. Avoid repeated freeze/thaw cycles. |
| 注意事项 | This product as supplied is intended for research use only, not for use in human, therapeutic or diagnostic applications. |
| 背景资料 | This gene encodes a nuclear phosphoprotein that plays a role in maintaining genomic stability, and it also acts as a tumor suppressor. The encoded protein combines with other tumor suppressors, DNA damage sensors, and signal transducers to form a large multi-subunit protein complex known as the BRCA1-associated genome surveillance complex (BASC). This gene product associates with RNA polymerase II, and through the C-terminal domain, also interacts with histone deacetylase complexes. This protein thus plays a role in transcription, DNA repair of double-stranded breaks, and recombination. Mutations in this gene are responsible for approximately 40% of inherited breast cancers and more than 80% of inherited breast and ovarian cancers. Alternative splicing plays a role in modulating the subcellular localization and physiological function of this gene. Many alternatively spliced transcript variants, some of which are disease-associated mutations, have been described for this gene, but the full-length natures of only some of these variants has been described. A related pseudogene, which is also located on chromosome 17, has been identified. [provided by RefSeq, May 2009]. |
| 应用 | 推荐稀释比例 |
| {IHC-P} | {1:100-500} |
| {IHC-F} | {1:100-500} |
| {IF} | {1:100-500} |

Antigen retrieval: citrate buffer ( 0.01M, pH 6.0 ), Boiling bathing for 15min; Block endogenous peroxidase by 3% Hydrogen peroxide for 30min; Blocking buffer (normal goat serum,C-0005) at 37℃ for 20 min;
Incubation: Anti-BRCA1/BAP1 Polyclonal Antibody, Unconjugated(bs-0802R) 1:200, overnight at 4°C, followed by conjugation to the secondary antibody(SP-0023) and DAB(C-0010) staining

风险提示:丁香通仅作为第三方平台,为商家信息发布提供平台空间。用户咨询产品时请注意保护个人信息及财产安全,合理判断,谨慎选购商品,商家和用户对交易行为负责。对于医疗器械类产品,请先查证核实企业经营资质和医疗器械产品注册证情况。
文献和实验[IF={{ 2.629 }}] {Huang Xianghua. et al. Expression of PD-L1 and BRCA1 in Triple-Negative Breast Cancer Patients and Relationship with Clinicopathological Characteristics. Evid-Based Compl Alt. 2021;2021:5314016} {IHC} {Human}
[IF={{ 2.608 }}] {Ji K et al. Differential Expression of lncRNAs and predicted target genes in normal mouse melanocytes and B16 cells. Experimental Dermatology. 2018.} {WB} {Mouse}
= NAL), appears to form upon oxidative cyclization of the nonfluorescent 2:1 lysine-HNE Michael adduct-Schiff base cross-link (Scheme 1). Polyclonal antibody (PAb) to the NAL-HNE fluorophore was raised in rabbit and found to be highly specific
GE Healthcare Benzamidine Sepharose™ 6B is p-aminobenzamidine covalently attached to Sepharose 6B by the epoxy coupling method. p-Aminobenzamidine (PAB), is a synthetic inhibitor of trypsin-like serine protease. Trypsin and trypsin
Studies of the Ubiquitin Proteasome System
Assays of E1 and E2 Activity Basic Protocol 1: Thiolester Formation Between Rabbit E1 and Ubiquitin Basic Protocol 2: Thiolester Formation Between E2 and Ubiquitin Binding of Ubiquitin‐Proteasome Proteins Basic Protocol 3: Binding of E2s to E3s Alternate
技术资料暂无技术资料 索取技术资料





